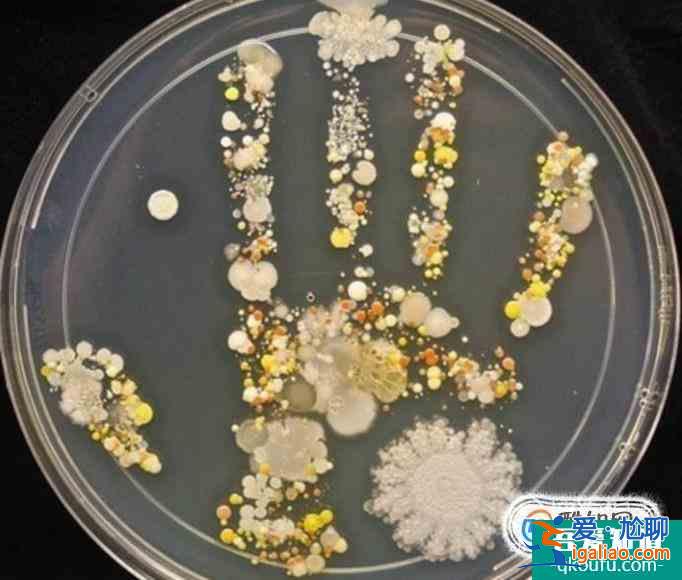
細菌菌落和真菌菌落的區別是什么?? 細菌菌落和真菌菌落的區別是什么??
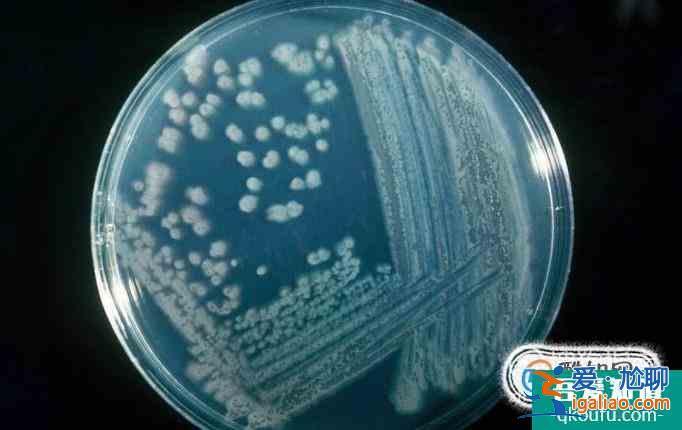
細菌菌落和真菌菌落的區別是什么?? 細菌菌落和真菌菌落的區別是什么??

細菌菌落和真菌菌落的區別是什么??
<愛尬聊_百科網>在初中生物中,我們要了解什么是真菌和細菌,所以在章節學習中我們學習到了菌落,菌落就是細菌或真菌繁殖后形成肉眼可見的集合體,下面小編就給大家講講真菌和細菌菌落的區別是什么。
操作方法01首先通過肉眼直接觀察可以看出,細菌菌落比較小,而真菌的菌落相對要大一些。細菌的菌落要仔細觀察才能夠看見。

在顏色方面,細菌的菌落一般是白色,透明,黃色,細菌的顏色比較淡。而真菌的顏色非常多,更加豐富。真菌一般有綠色,黑色,褐色,黃色,綠色等多種顏色。
在形態方面,細菌菌落表面一般光滑粘稠,不然就是粗糙干燥。而真菌確實毛茸茸的,或者像蜘蛛網一樣,甚至還有絮狀的。
正確區分細菌菌落和真菌菌落,不僅能夠更好地學習生物,也非常有利于日常生活。像我們生活中橘子發霉,橘子表面就是真菌菌落。

